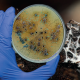
El bioma: el espacio que gana relevancia

El bioma: el espacio que gana relevancia
El Dr. Patrick Brown, académico e investigador de la Universidad de California Davis, destaca la importancia con que se trató la interacción entre las plantas con los microorganismos, para el buen diseño de estrategias biológicas en los cultivos.
Por Felipe Aldunate
Uno de los puntos más novedosos del 2do Congreso de Bioestimulantes y Biocontrol organizado por Redagrícola a fines de septiembre fue el énfasis en lo que sucede bajo el suelo: la asombrosa relación que se da entre los microorganismos con las raíces. Así lo señaló el Dr Patrick Brown, distinguido académico de la Universidad de California en Davis y uno de los referentes mundial en desarrollo de la investigación de biológicos para la agricultura.
“Uno de los aspectos que ha sido muy revelador e interesante en este Congreso de biológicos, más que en cualquier otro al que haya asistido anteriormente, es el énfasis en el microbioma”, señaló Patrick Brown. “Ha sido un énfasis que no solo se ha dado en el área de los biopesticidas, sino también en el de biofertilizantes y especialmente en los bioestimulantes. Es una muestra de la importancia de pensar en estos productos como un continuo, y no como categorías de productos discretos y oportunidades discretas”.
Brown fue el responsable de la exposición de cierre de este Congreso realizado en Lima, Perú, y en el que destacó varias de las ideas que presentaron más de 30 expositores en 40 distintas charlas y paneles de conversación. En este contexto, Brown destacó los aportes que distintos investigadores presentaron sobre la necesidad de abordar estrategias biológicas integrales y que tengan al bioma que se da en el suelo, en las hojas y al interior de las plantas, como objetivo.
«Al igual que los biofertilizantes y los biopesticidas, los bioestimulantes están empezando a ser usados masivamente. Estamos en una ventana donde la aceptación se está produciendo».
En su intervención, Brown destaca el importante crecimiento que ha tenido la industria de los biológicos y de cómo los bioestimulantes se están sumando a los biocontroladores y biofertilizantes en el uso masivo en los cultivos. Esto, pese a las dificultades que tienen para ser testeados y validados. “Estos productos son utilizados en un trasfondo de estrés ambiental, el cual es muy diverso y muy impredecible”, dice Brown. “Siempre se plantea la cuestión de si estamos tratando con agua con azúcar o si son insumos realmente valiosos para el entorno agroquímico. Al igual que los biofertilizantes y los biopesticidas, los bioestimulantes están empezando a ser usados masivamente. Estamos en una ventana donde la aceptación se está produciendo. Es un momento clave de altas obligaciones para los fabricantes de estos productos quienes deben asegurarse de que lo que ofrece sea realmente biorracional. De lo contrario, terminarán destruyendo su propio mercado con productos que no valen la pena”.
BIOESTIMULANTES Y SU FUNCIÓN ANTI ESTRÉS
Tras ello, Brown se refiere a un artículo suyo de 2015 y en el que plantea que la función que están cumpliendo los bioestimulantes es mitigar el estrés. “La hipótesis era que en todos los sistemas agrícolas hay períodos de estrés en los que rara vez se alcanza la máxima productividad”, dice. “Obviamente, no se obtienen rendimientos récord todos los años, aunque nos gustaría obtener rendimientos récord todos los años”.
Bajo este contexto, y citando la presentación del científico español Enrique Monte, Brown señala que “lo que probablemente hacen los bioestimulantes es reconstruir la resistencia natural y la capacidad de recuperación natural del sistema. Así es como abordan e influyen en la mitigación del estrés de las plantas”.
En este punto, Brown destaca que, tal como se vio en varias de las charlas durante el Congreso, esto probablemente se debe en gran medida a una interacción con el microbioma. “Creo que hemos subestimado cómo el microbioma es una parte fundamental de la evolución, de la resistencia y de la adaptación de los cultivos”, señala. “La hipótesis del microbioma dice simplemente que los microbios del medio ambiente sirven como mecanismo de detección para las plantas. También sirven como algunos de los mecanismos de respuesta para las plantas en un bucle de retroalimentación. Uno podría preguntarse por qué los microbios harían eso. La respuesta es que han coevolucionado con las plantas durante los últimos 500 millones de años y que les interesa que la planta fotosintética siga siendo productiva porque, en última instancia, es la fuente de todos los alimentos de la tierra”.
«Creo que hemos subestimado cómo el microbioma es una parte fundamental de la evolución, de la resistencia y de la adaptación de los cultivos»
Es esto, destaca Brown, lo que permite que cuando uno llega a un ecosistema natural, la productividad sea tremendamente mayor. “Es más alta porque en este sistema hay individuos que pueden llenar cada nicho, individuos que pueden responder cambios ambientales. Una sequía, para uno, es una oportunidad para otro. Una inundación para uno es una oportunidad para otro. La escasez de fósforo es una oportunidad”, dice. En estos sistemas, añade, siempre hay un individuo que puede aprovechar esa condición particular, para lo cual los microbios son fundamentales en este proceso.
LOS FACTORES DEL CRECIMIENTO
Brown destacó en sus conclusiones las razones por la que cerca de 1.500 asistentes de más de 20 países participaron durante los dos días del congreso realizado en el Hotel Westin de Lima.
“La razón por la que estamos aquí es por el crecimiento tremendo que ha registrado esta industria, y que sigue creciendo en 10-15% anual”, dice. “Es una industria emocionante y que ha hecho muchos progresos en los últimos 15 años”.
Brown destacó algunas ideas de Matthew Meisner, de Farmer Business Network, para explicar los factores que impulsan esta expansión. En esto destaca la oportunidad de mayor rentabilidad para la industria farmacéutica, la agroquímica y la agrícola. A eso suma el alza en el precio de los insumos convencionales para el campo, como fertilizantes, así como la mayor resistencia a químicos tradicionales. “Cuando hablo con agricultores, veo esto como una de las fuerzas principales de crecimiento: los agricultores están conscientes de que los productos agroquímicos y los fertilizantes son perjudiciales, por lo que buscan alternativas. Los estimulantes, los biofertilizantes parecen haber ganado atención con ese fin”, dice. A esto suma la cada vez menor innovación en la química tradicional para los nuevos desafíos agrícolas y una mayor demanda por los grandes clientes agrícolas, como supermercados y otros compradores, por desarrollar una industria biorracional y bioprotegida.
Esto ha impulsado un fuerte movimiento de innovación y de nuevas empresas, “así como tiburones que están interesados en incorporar a pequeños jugadores, y que han impulsado un tremendo proceso de consolidación”.

FRONTERAS CADA VEZ MÁS DIFUSAS
Brown agrega a esto los cada vez más notorios efectos del cambio climático y las nuevas fuentes de estrás abiótico que enfrentan las plantas y que es campo donde juegan los bioetsimulantes. Explica que el potencial de rendimiento de un cultivo está definido por la genética, por el entorno, por la disponibilidad de sol y agua, y otros elementos. “Pero a medida que se avanza en la temporada, se producen acontecimientos y se pierde rendimiento, de modo que el resultado final realizado nunca es tan grande como el potencial”, dice. “El lugar teórico en el que funcionan los bioestimulantes es en esta etapa de adaptación del rendimiento, de mitigación del rendimiento, independientemente de si es a través de la tolerancia al estrés térmico, o la tolerancia al estrés hídrico o los efectos de la deficiencia de nutrientes. Todas estas son versiones de estrés”.
Se trata de un ámbito distinto al que tradicionalmente se asignan a biocontroladores y biofertilizantes, conceptos que son utilizados en el mercado para identificar las distintas categorías de biológicos. Señala que las regulaciones vigentes los tratan como productos separados, pese a que las fronteras entre ellas en el uso agrícola son cada más difusas. “Ciertamente hemos visto que los biofertilizantes y los bioestimulantes se están fusionando”, dice. En eso destacó la presentación de la científica colombiana Alba Marina Cotes. “Estos productos trabajan en conjunto, son un continuo, tal como lo vimos en la excelente presentación de la Dra. Alba Marina Cotes, quien ilustró como estas piezas trabajan juntas. No es sólo el genoma de las plantas y la capacidad de éstas para crecer y sintetizar hormonas. Es una red de microbios y plantas que trabajan juntos para crear la base utilizada, la sinergia óptima y la eficacia del sistema en su conjunto”, dice.
Otro ejemplo de esto fue en la charla de Trichoderma, realizada por el Dr Enrique Monte. “Fue muy interesante ver todo el amplio espectro de efectos que Trichoderma puede tener: puede ser parasitismo, puede ser antibiótico, puede ser enzimático y control de microbios. Puede ser competencia. También, puede ser bioestimulación. Y vemos que con muchos de los microbios del suelo muy activos tienen este efecto multifuncional que habla del efecto de ecosistema del que estamos hablando”.
EFECTOS HOLÍTISCOS
Brown destacó también, en esta misma línea, las presentaciones sobre sustancias húmicas, y el amplio espectro de efectos que puede tener sobre las plantas y su ecosistema, tal como lo señaló el científico español David de Hita en su presentación. “Vimos una sugerencia aquí que a veces los efectos son holísticos. Puedes tener un efecto por encima del suelo. Puedes tener un efecto bajo tierra y un resultado integrado que es mayor que la suma de las partes”, dice. “Hubo muchos casos en el Congreso en los que los ponentes se centraron en los efectos de los bioestimulantes en las poblaciones microbianas. Ilustraron cómo un sistema totalmente natural es abundante en diversidad microbiana, mientras que un sistema degradado, tal como lo son la mayoría de nuestros sistemas agrícolas, está agotado en muchos microorganismos. Señalaron cómo se puede potencialmente manipular esa rizosfera, cómo puede gestionar el suelo para que regrese de nuevo a su salud natural original”.
En este sentido planteó una pregunta que puede servir de base para nuevas investigaciones. “Si esto es cierto, se podría suponer que un suelo completamente funcional y sano no respondería a un bioestimulante, porque no necesita reemplazar lo agotado. Y eso sería una interesante serie de experimentos para ver si eso es de hecho cierto”, explica.
UNIVERSOS Y DEFINICIONES POR DESCUBRIR
Sobre las algas, Brown destacó que sólo hay cinco o seis especies de algas que se utilizan en la industria de bioestimulantes, rescatando un dato de la Dra Izabella Michalak. Esto pese a que hay “más de 6.000 algas rojas y marrones, así como cerca de 80.000 microalgas”, dice. “Así que hay una enorme cantidad de oportunidades allí. También hay oportunidad en la forma de hacer extracciones”.
Destacó que en el Congreso se hablara de proteínas hidrolizadas como bioestimulantes, pese a que se usan muy poco en EE.UU. y en Norteamérica en general. Agrega a eso el silicio y la dificultad de definir sus funciones. Citando al científico brasileño Fabrício Ávila Rodrigues, quien hizo dos presentaciones de silicio en la conferencia, Brown señaló que “estas demostraron que el silicio tiene funciones nutricionales, bioestimulantes y patogénicas”. Un tópico que lo llevó nuevamente al aspecto normativo, pues, según la regulación europea de 2019, un bioestimulante es un producto fertilizante independiente de su contenido de nutrientes. “Así que ahora piensa en el silicio. Es como decir ‘ok, que no sea un nutriente’, y sin embargo es un elemento único, que por todas las definiciones debiera ser un nutriente. Estamos atrapados en este círculo tonto”.







